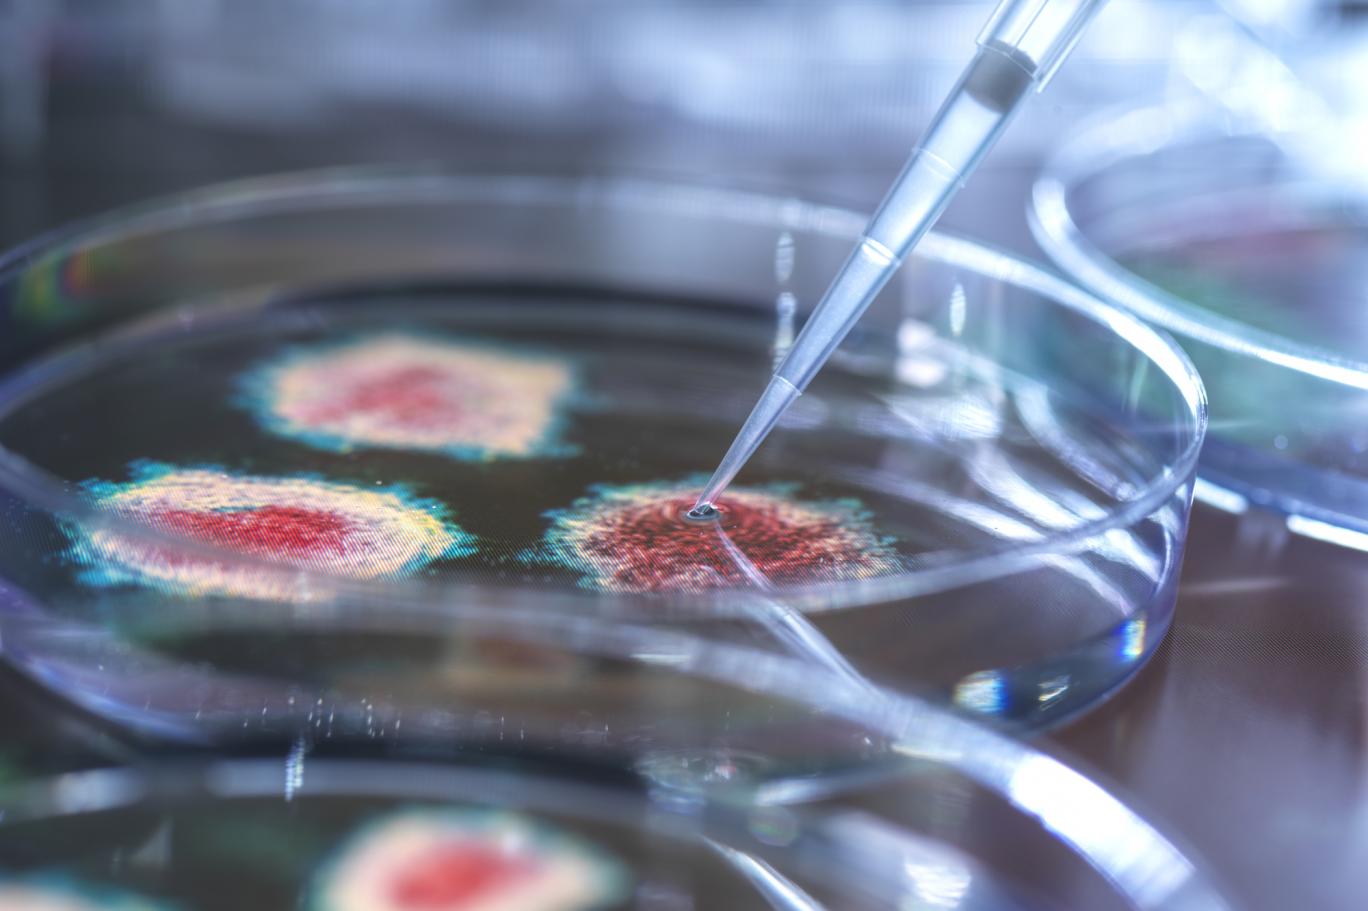

السلالة الجديدة في الموجة الثانية لكورونا تهدد بانهيار النظام الصحي
حذرت وزارة الصحة من مخاطر كبيرة من ارتفاع الاصابات بفيروس كورونا عبر موجة ثانية قد تكون أقسى من الاولى كما يحدث في العديد من الدول.
وقالت الوزارة في بيان انه أنطلاقا من مسؤولياتها تتابع الموقف الوبائي المحلي والدولي بسبب وجود هذه المخاطر لاسباب عدة منها، ان امد المناعة التي تمنحها الاصابة لا زال غير معروف وامكانية الاصابة مرة اخرى محتملة جدا ومن الخطأ التعويل عليها وترك الاجراءات الوقائية.
واضافت ان التحور المستمر بسلالات الفيروس كما حدث في دول بريطانيا وجنوب افريقيا و البرازيل وكان هذا التحور السبب في سلالات اشد انتشاراً من السلالة القديمة في ٥٠ دولة لحد الان ، ومن المحتمل ان يحدث تحور بالسلالة في بلدنا او ينتقل الينا من البلدان الاخرى.
كما اشرت الوزارة ما وصفته بالتهاون الكبير بالاجراءات الوقائية من قبل المؤسسات الحكومية وغير الحكومية والقطاع الخاص من خلال ملاحظات و رصد فرقنا الصحية حيث الضعف الواضح في الالتزام بهذه الاجراءات والتعمد في خرق التعليمات الصادرة عن اللجنة العليا للصحة والسلامة الوطنية.
وحذرت ايضا من فتح كافة المرافق الحيوية والمراقد الدينية وعودة الحياة الطبيعية بشكل كامل الى هذه المرافق ذات التجمعات البشرية الضخمة بدون الالتزام بقواعد التباعد الاجتماعي، منوهة الى ان فصل الشتاء وانخفاض درجة الحرارة يعتبر عامل مساعد لانتشار الوباء.
وأكدت كل ذلك يشكل خطراً كبيرا ويوفر بيئة مناسبة لحدوث ارتفاع الاصابات بموجة ثانية قاسية قد تهدد النظام الصحي ويذهب بكل ما تم تحقيقه خلال الاشهر الماضية.
وشددت على ان الوضع الوبائي لم ينحسر بعد وان التصاعد المستمر في نسب الشفاء والانخفاض بالاصابات والوفيات جاء نتيجة جهود مضنية بذلتها وزارة الصحة بكوادرها المتقدمة وبجيشها الابيض وبامكانياتها المتواضعة من خلال خططها الرصينة التي تكللت بالتوسع الذي حدث في المجالات التشخيصية والعلاجية والوقائية خلال السبعة اشهر الماضية وتكبدت هذه الوزارة خلال هذه المعركة الشرسة أكثر من 180 شهيدا من جيشها الابيض واكثر من 28 الف اصابة.
وطالبت الوزارة المواطنين بالتقيد التام بالاجراءات الوقائية وعدم التهاون بها وخاصة بارتداء الكمام والتباعد الجسدي وتعقيم اليدين باستمرار والابتعاد عن التجمعات البشرية المكتظة والاماكن المغلقة.
كما شددت على الفرق الصحية الرقابية بالاستمرار بمتابعة تطبيق الاجراءات الوقائية في المدارس وفق قرارات اللجنة العليا للصحة والسلامة الوطنية وتكثيف التحري باخذ المسحات من الطلبة وكذلك متابعة المطاعم والمقاهي والمولات والمتنزهات واتخاذ الإجراءات القانونية بحق المخالفين.
وأكدت ان على مؤسسات الدولة كافة على الالتزام بالاجراءات الاحترازية داخل المؤسسات وخاصة عند اقامة اي نشاطات ذات تجمعات بشرية من شانها تزيد خطر العدوى بين المشاركين.واردفت ان وزارة الصحة تطمئن المواطنين الكرام بانها مستمرة بالتنسيق مع الشركات المنتجة للقاح كوفيد ١٩ لتوفيره باسرع وقت ممكن بعد اعتماده من المنظمات العلمية الدولية الرصينة لضمان فعالية ومأمونية اللقاح.



